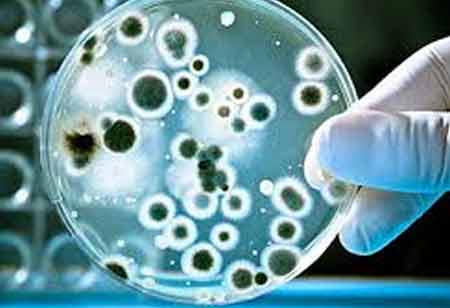

Bacteria in Hot Tubs: What You Need to Know
Thank you for Subscribing to Medical Care Review Weekly Brief
By
Medical Care Review | Friday, June 14, 2024
Stay on top of your health and well-being with exclusive feature stories on the top medical clinics and treatment centers, expert insights and the latest news delivered straight to your inbox. Subscribe today.
Some of the bacteria found in hot tubs include Escherichia coli, norovirus, cryptosporidium (Crypto), and giardia.
FREMONT, CA: Hot tubs may be a relaxing and unwinding experience if they are kept clean, well-maintained, and at the proper temperature. However, they can also serve as a breeding ground for microorganisms that cause diarrhea. Hot tubs can be relaxing, but some safety concerns should be considered. Like swimming pools, hot tubs must be kept clean and disinfected to avoid germ-related health problems. This involves diarrhea.
If individuals have three or more loose stools in a day, they may have diarrhea. Depending on the underlying reason, diarrhea might induce abdominal pain, cramps, or flu-like symptoms. Simply sitting in a hot tub is unlikely to cause diarrhea. Instead, the presence of specific microorganisms in the water, such as bacteria, parasites, and viruses, can cause illness and subsequent diarrhea when exposed to them.
Prevalent types of bacteria that could be present in hot tubs or pools are:
Giardia: Another kind of parasite that enters pools and hot tubs through the stool of infected individuals is called giardia. It is known to cause diarrhea twice to five times a day, as well as fatigue. Symptoms may persist for several weeks.
Cryptosporidium (crypto): This parasite can live in water, food, and surfaces. It spreads through the stools, and the most frequent symptom is diarrhea. Infections can last from 1 to 2 weeks.
Norovirus: Norovirus is the most common cause of diarrhea and vomiting in the United States. It can be transmitted by infected water and food. Symptoms may appear within 12 hours of exposure and remain for one to three days.
Escherichia coli (E.coli): E. coli causes diarrhea and is passed on through contaminated food, water, or direct contact with sick people.
Shigella: Shigella is a bacteria that causes diarrhea and can spread through contaminated water and food. Symptoms can develop within one to two days and persist for up to a week. This infection can cause bloody diarrhea.
If these bacteria are present in a hot tub and the contaminated water comes into contact with mucous membranes in one's nose or mouth, they may become ill. Even if a tub or pool appears to be clean and well-maintained, it may still contain germs that cause diarrhea. Some may survive for a few minutes, while others may survive for days in chlorinated water. If someone infected with these germs uses the hot tub, they may also contract the illness. This is especially true if they mistakenly consume any of the contaminated water.
For these reasons, public pool operators frequently advise avoiding entering the water if people are experiencing diarrhea. While some germs can be cleansed using filters and chemicals, they may not be eliminated before reaching other people.
However, if you would like to share the information in this article, you may use the link below:
https://www.medicalcarereview.com/news/bacteria-in-hot-tubs-what-you-need-to-know-nwid-514.html